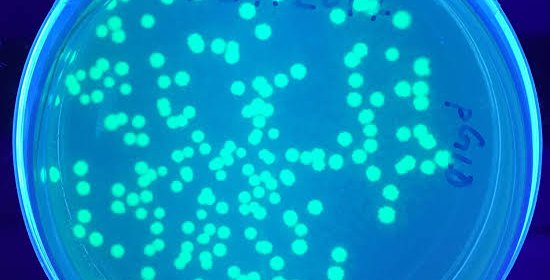

This team has not shared any details yet. Please check back for updates.
This team has not shared any details yet. Please check back for updates.
Space exploration involves overcoming numerous challenges: extreme gravity, disrupted sleep and circadian rhythms, limited supplies, and access to medical care, etc. Your challenge is to design a platform that allows users to explore space travel stresses, understand how diverse organisms deal with these stresses, and then build a “Space Biology Superhero” by combining features from these organisms.
